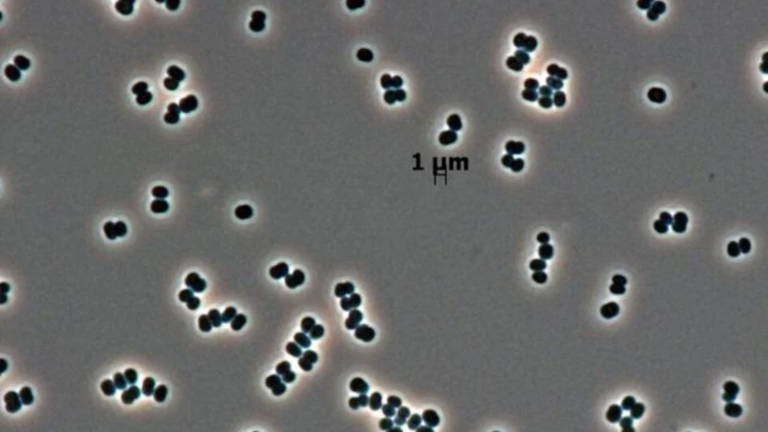
Así es la superbacteria que se infiltró en la NASA y que muy posiblemente hayamos enviado sin querer a Marte

Así es la superbacteria que se infiltró en la NASA y que muy posiblemente hayamos enviado sin querer a Marte
La 'Tersicoccus phoenicis', descubierta en las salas más esterilizadas del mundo, posee la habilidad de entrar en un estado de latencia indetectable, planteando una serie de incógnitas sobre su supervivencia extraplanetaria
En los lugares donde se ensamblan naves para viajar a otros mundos, la esterilidad es una religión, salas con filtros de aire de alta eficiencia, desinfectantes químicos agresivos y tratamientos con radiación y calor se diseñan para erradicar toda forma de vida microbiana, sin embargo, una bacteria ha logrado burlar este sistema de defensa casi perfecto.
Se llama Tersicoccus phoenicis, y su única habilidad conocida es sobrevivir donde nada más puede, simulando estar muerta hasta que las condiciones le sean favorables, el descubrimiento de este microorganismo se dio en dos lugares; primero, en una sala limpia en el Centro Espacial Kennedy de la NASA en Florida (Estados Unidos) y luego en el Centro Espacial Guyanais en Kourou (Guayana Francesa), localizaciones separadas por más de 4,000 kilómetros.
La estrategia del "muerto viviente"
La presencia de este organismo en ambientes tan extremos y aislados fue la primera señal de que se trataba de uno con capacidades excepcionales, ahora, un nuevo estudio liderado por la Universidad de Houston y publicado en la revista Microbiology Spectrum ha descifrado su estrategia de supervivencia, revelando un mecanismo que preocupa a los científicos encargados de la protección planetaria.

La mayoría de las bacterias que sobreviven en ambientes hostiles lo hacen formando alguna especie de capa de resistencia, Tersicoccus phoenicis es distinta, su método es más sutil y, por ello, más difícil de detectar: entra en un estado de "coma" profundo, cuando se ve privada de nutrientes y es sometida a desecación, la bacteria reduce su actividad metabólica a niveles casi imperceptibles, deja de crecer y de reproducirse, volviéndose "invisible" para los métodos de monitoreo microbiológico convencionales, que buscan signos de vida activa.
"Estos hallazgos resaltan la resiliencia de los microbios asociados a las naves espaciales y representan una gran preocupación para la protección planetaria", explicó Madhan Tirumalai, líder de la investigación, en esencia, la bacteria "simula su muerte" para escapar de los rigurosos tratamientos de limpieza. Lo más sorprendente es que puede permanecer en este estado durmiente durante meses o incluso años, esperando el momento oportuno para reactivarse.
El equipo de la Universidad de Houston logró demostrar este mecanismo en el laboratorio, tras someter a la bacteria a condiciones extremas, comprobaron que podían "despertarla" de su letargo añadiendo una proteína específica, similar a la utilizada para reactivar a la Mycobacterium tuberculosis, la bacteria causante de la tuberculosis (valga la redundancia).
La gran pregunta, y la que más alarma genera, es si esta bacteria pudo viajar inadvertidamente en alguna misión, una de las salas donde fue identificada por primera vez se utilizaba para los preparativos de la misión Phoenix a Marte, aunque los expertos consideran que las probabilidades de que sobreviva en la superficie marciana, expuesta a radiación intensa y condiciones extremas, son bajas, la posibilidad existe y no puede descartarse.
Por improbable que sea, me resulta gracioso pensar en la posibilidad de que nos hayamos cargado a una especie inteligente de marcianos por haber mandado sin querer a su planeta una bacteria indetectable por su sistema inmunológico, al más puro estilo "La guerra de los mundos".